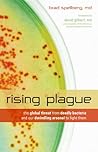
Rising Plague: Th...

“I have learned that if you must leave a place that you have lived in and loved and where all your yesteryears are buried deep, leave it any way except a slow way, leave it the fastest way you can. Never turn back and never believe that an hour you remember is a better hour because it is dead. Passed years seem safe ones, vanquished ones, while the future lives in a cloud, formidable from a distance.”
― West with the Night
― West with the Night

“Shakespeare said that art is a mirror held up to nature. And that’s what it is. The nature is your nature, and all of these wonderful poetic images of mythology are referring to something in you. When your mind is trapped by the image out there so that you never make the reference to yourself, you have misread the image.
The inner world is the world of your requirements and your energies and your structure and your possibilities that meets the outer world. And the outer world is the field of your incarnation. That’s where you are. You’ve got to keep both going. As Novalis said, 'The seat of the soul is there where the inner and outer worlds meet.”
― The Power of Myth
The inner world is the world of your requirements and your energies and your structure and your possibilities that meets the outer world. And the outer world is the field of your incarnation. That’s where you are. You’ve got to keep both going. As Novalis said, 'The seat of the soul is there where the inner and outer worlds meet.”
― The Power of Myth

“I don't have to have faith, I have experience.”
― The Power of Myth
― The Power of Myth

“I am incapable of a profound remark on the workings of Destiny”
― West with the Night
― West with the Night

“We're so engaged in doing things to achieve purposes of outer value that we forget the inner value, the rapture that is associated with being alive, is what it is all about.”
― The Power of Myth
― The Power of Myth
 Support for Indie Authors
— 16640 members
— last activity Mar 07, 2026 04:19AM
Support for Indie Authors
— 16640 members
— last activity Mar 07, 2026 04:19AM
Officially 15k Members Strong & Climbing!! Building and supporting a community of self-published authors dedicated to both sharing experiences and le ...more
 The Reading For Pleasure Book Club
— 3840 members
— last activity 2 hours, 51 min ago
The Reading For Pleasure Book Club
— 3840 members
— last activity 2 hours, 51 min ago
This is a book club where we will share our current reads in ebooks, regular books, audiobooks, graphic novels and more. This is where we can all shar ...more
Ray’s 2025 Year in Books
Take a look at Ray’s Year in Books, including some fun facts about their reading.
Ray hasn't connected with her friends on Goodreads, yet.
Polls voted on by Ray
Lists liked by Ray